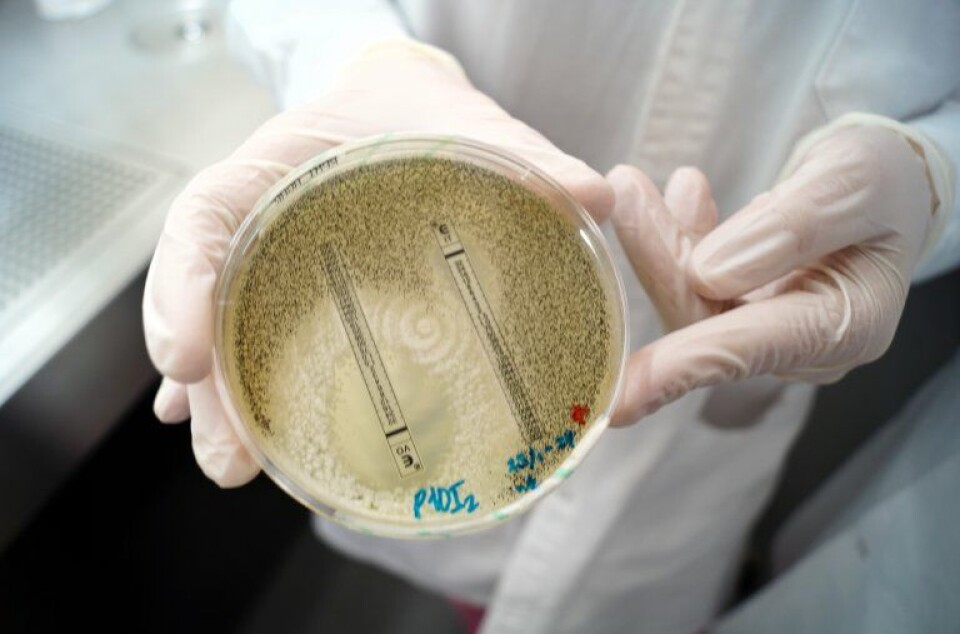

THIS CONTENT IS BROUGHT TO YOU BY NIBIO - Norwegian Institute of Bioeconomy Research - read more

Fungicide resistance is a threat to the health of humans, animals, and plants
Fungicides are important in the fight against harmful fungi, but researchers are concerned about the development and spread of fungicide-resistant fungi.
Fungi can cause disease in humans, animals, and plants. Every year, 1.5 million people die from fungal infections. Fungal attacks in food crops threaten food production.
To protect ourselves, we have developed chemical agents in the form of medicines or pesticides. These kill harmful fungi.
The most effective remedy against fungal infections is a group of substances collectively known as azoles.
“It is vital that the azoles we use against pathogenic fungi have a good effect,” says Ida Skaar, senior researcher at the Norwegian Veterinary Institute.
Azoles are indeed frequently used as medicine for humans and animals, to prevent fungal diseases in food crops and on golf courses, to preserve wood, to prevent mould in flower bulbs and silage, and to preserve ornamental plants.
The list is long. This frequent use causes researchers to worry because the harmful fungus develops resistance.
A little-explored topic
Antibiotic resistance is a well-known issue that raises concern among many. In comparison, fungicide resistance is a little-explored, but very relevant, topic.
The World Health Organization (WHO) has singled out the fungus Aspergillus fumigatus as a fungus that can pose a health threat in the future. A. fumigatus is a common fungus found everywhere.
It poses little threat to healthy people. For people with a compromised immune system, it can cause infections that need to be treated. In such cases, it is vital that the medicine, which is usually based on azoles, is effective.
“A. fumigatus that is resistant to azoles is an increasing global problem,” Skaar says.
She explains that we do not know how the situation is in Norway, but with the wetter and warmer climate that can probably be expected in the future, the problem will become greater.
“Knowledge about the situation in Norway is absolutely necessary. We must be proactive and have the necessary knowledge before the problem becomes too serious. We must, among other things, know how much resistance we have, in what way the fungus develops resistance, and in which environments resistance is likely to arise, so-called hotspots,” she says.

One Health – everything is connected
Skaar leads the project NavAzole which aims to map and understand the development of azole resistance in Norway. This knowledge is needed to make wise decisions to keep the resistance level as low as possible. This requires cooperation between different sectors.
“Azole resistance concerns several sectors. We must therefore keep the One Health perspective in mind when working with it. This means that we must acknowledge the important connection between human health, animal health, and the surrounding environment," Skaar says.
She explains that it is important to look at how azoles are used, investigate hotspots for resistance development, and how resistance is spread further.
Looking for resistance in soil-dwelling fungi
A potential hotspot for resistance development is the use of azole-based pesticides in agriculture. Researchers at NIBIO will work on this issue in the project.
Andrea Ficke works with fungal diseases in cereals. She explains how a cereal field can be a hotspot for resistance development:
“A. fumigatus is a soil-dwelling fungus that also exists in the field. In conventional agriculture, the crops are sprayed against various fungal diseases, and many of the fungicides are based on azoles. Some of the fungicides will end up in the soil and can affect A. fumigatus. In the same way that a high use of antibiotics can lead to bacteria developing resistance, regular exposure to azoles can lead to resistance in A. fumigatus.”
In the project, the researchers therefore want to investigate whether they find resistant A. fumigatus in cereal fields that are sprayed with azole-based fungicides, and whether there is a correlation between resistance development in plant pathogenic fungi and resistance development in A. fumigatus.
The researchers are going to study two fungi that cause the leaf blotch diseases septoria leaf blotch (Zymoseptoria tritici) and septoria nodorum blotch (Parastagonospora nodorum).
"These diseases can lead to a considerable loss of crops,” Ficke says.
Ficke has been working on leaf blotch diseases in cereals for 10-12 years. During these years, she has not observed a worrying increase in resistance to fungicides.
So far, Skaar's research group has also not found resistant A. fumigatus in fields. However, this does not mean that we can become complacent; rather, quite the contrary.
Preventive work is important
“In Norway, we are very fortunate not to have major problems with fungicide resistance in crops,” Ficke says.
Although Skaar has found more resistant A. fumigatus in various Norwegian environments than expected, she also believes that the problem is relatively small in Norway.
“But you don't have to go further than to Denmark before the situation is more serious,” she says.
Both researchers emphasise the importance of focusing on this issue in Norway.
“The preventive efforts we put in are crucial. We must understand the extent of the problem in Norway, and we must implement measures that can reduce the development of resistance," Skaar says.
The use of integrated pest management plays an important role in this, by reducing unnecessary use of fungicides. Additionally, it is important to evaluate the situations where the use of fungicides is necessary.

“Norway excels at avoiding unnecessary use of antibiotics, and we should focus equally on avoiding unnecessary use of fungicides. When resistance becomes properly established, it's very difficult to eradicate. Therefore, we must be proactive,” Skaar concludes.
How fungi develop resistance
In all fungal populations, there exists a certain genetic variation. This variation can make some ‘individuals’ more tolerant to the exposure to fungicides than others.
When the population is exposed to fungicides, these individuals will survive, and can reproduce.
The resistance to fungicides is genetic, and thus hereditary. Random mutations can also occur in the DNA of the fungus, making it resistant. In this way, the use of the same type of fungicide over a long time will select for fungi that are increasingly resistant. The faster the fungi reproduce, the faster resistance can occur.
Different fungicides have different strategies to kill or inhibit fungi. An individual that has developed resistance to one type of fungicide is not necessarily resistant to a fungicide that works in a different way.
Therefore, it is important to avoid one-sided use of fungicides with the same mode of action. In addition, in plant production, one should use integrated pest management (IPM) to reduce the need for fungicides and other pesticides.

This content is paid for and presented by NIBIO - Norwegian Institute of Bioeconomy Research
This content is created by NIBIO's communication staff, who use this platform to communicate science and share results from research with the public. NIBIO is one of more than 80 owners of ScienceNorway.no. Read more here.
More content from NIBIO:
-
This colourful bird is thriving in Norway
-
Can drone-mounted tree planting replace manual tree planting?
-
Light traps can tell us more about nocturnal moths
-
Climate change and land use threaten Sámi reindeer husbandry
-
Researchers are now going to monitor carbon in forest and grassland soils
-
Nine facts about Norwegian agriculture